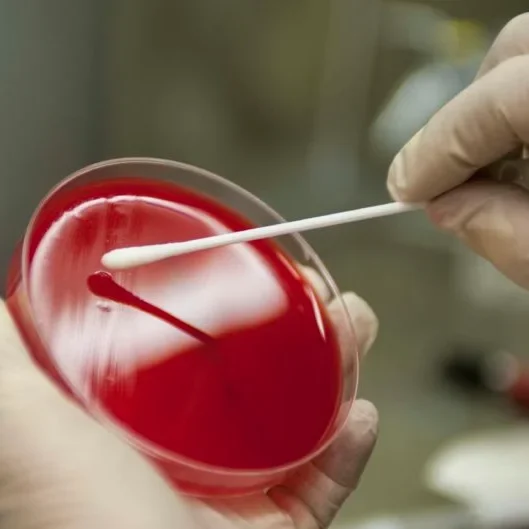

Welcome to Spora
Best Sellers
Health Supplements
We offer 30 ml tinctures of four potent mushroom species, as well as an all-in-one complex blend, and a gentle formula created especially for pets.
For manufacturers and retailers, our 1-liter wholesale tinctures provide the same exceptional quality in bulk. All of our tinctures are alcohol-free, glycerine-free, and made with only natural preservatives for clean, effective nourishment.
Prefer capsules? Choose from our vegan or gelatin capsule options, each designed to deliver the natural benefits of mushrooms with purity and ease.


Wholesale Division
Empowering Your Business with Quality Products, Tailored Solutions and Expert Sourcing!
We offer an extensive range of high-quality products at wholesale, to meet the diverse needs of businesses in the mushroom and broader agricultural industries.
Whether you’re a retailer, distributor, or other wholesale partner, we provide customised service with flexible contract options to ensure you get the best value and consistent supply.
With our deep industry expertise, we can source specialised products for the broader agricultural sectors, helping you stay ahead of market trends.
Complete Kits
-
Growers Combo – Woodlovers
R850,00 -
Grow More Combo – Woodlovers
R1500,00 -
Growers Combo – Craft
R300,00 -
Grow More Combo – Craft
R800,00 -
Mushroom Grow Kit
R120,00 -
Mushroom Grow Bag – Speciality
R120,00
We’d Love To Hear From You!
Share your ideas, feedback, and suggestions in our suggestion box — let us know what products or services you’d love to see from us in the future.